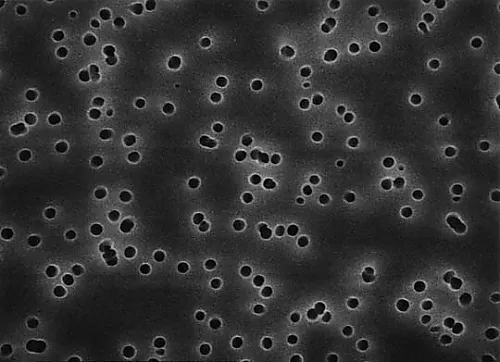

Analyzer, Testing Equipment
61-0209-23 Isopore Disc PC Philic 5.0μm 142mm Wh Pln 50/Pk 50PK TMTP14250
Product Description
Product Model: 61-0209-23Product Brand: Merck Millipore […]
Contact Us
Product Details
Product Model: 61-0209-23
Product Brand: Merck Millipore Corporation
Spec
- Filter bore diameter, μm: 5.0
- Filter diameter, mm: 142
- Thickness, μm: 7?22
- Material: Polycarbonate
- Filter color: White
- Filter code: TMTP
- Filter brand name: Isopore
- Brand name: Isopore
- Quantity/box: 50
-
Overview: Isopore membrane, polycarbonate, hydrophilicity, 5.0
μm, 142
mm, white, plain - Product name: Isopore membrane filter
- Filter type: Screen filter
- Filter surface: Plain
- Refractive index: 1.6
-
Extracts, %:
1 - Highest operating temperature, ℃: 140
-
Water flow rate, mL/min x cm
2
/psi: 250 - Wettability: Hydrophilic
-
Air flow rate, L/min x cm
2
/psi: 50 - Porosity %: 5?20
- ※We ask for your kind understanding that lead time might change If it is out of stock in Japan.
Related product recommendations
You may also be interested in the following products
62-8388-96 Anti-FSP1/S100A4; 100 μg 7-74
model: 62-8388-96
brand: Sigma Aldrich Japan(Millipore)
61-0190-57 1/4In. HB To M Luer Lock Nickel/Chrome Plated 1/Pk 1PK XX3002564
model: 61-0190-57
brand: Merck Millipore Corporation
62-8488-10 Leukemia Inhibitory Factor, recombinant human; 5 μg LIF1005
model: 62-8488-10
brand: Sigma Aldrich Japan(Millipore)